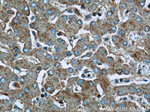
IDE Antibody in Immunohistochemistry (Paraffin) (IHC (P))

Search
Proteintech
IDE Polyclonal Antibody
{{$productOrderCtrl.translations['antibody.pdp.commerceCard.promotion.promotions']}}
{{$productOrderCtrl.translations['antibody.pdp.commerceCard.promotion.viewpromo']}}
{{$productOrderCtrl.translations['antibody.pdp.commerceCard.promotion.promocode']}}: {{promo.promoCode}} {{promo.promoTitle}} {{promo.promoDescription}}. {{$productOrderCtrl.translations['antibody.pdp.commerceCard.promotion.learnmore']}}
产品信息
21728-1-AP
种属反应
已发表种属
宿主/亚型
分类
类型
抗原
偶联物
形式
浓度
规格
纯化类型
保存液
内含物
保存条件
运输条件
产品详细信息
This antibody is specific to IDE.
Immunogen sequence: EQPHQHAMY YLRLLMTEVA WTKDELKEAL DDVTLPRLKA FIPQLLSRLH IEALLHGNIT KQAALGIMQM VEDTLIEHAH TKPLLPSQLV RYREVQLPDR GWFVYQQRNE VHNNCGIEIY YQTDMQSTSE NMFLELFCQI ISEPCFNTLR TKEQLGYIVF SGPRRANGIQ GLRFIIQSEK PPHYLESRVE AFLITMEKSI EDMTEEAFQK HIQALAIRRL DKPKKLSAEC AKYWGEIISQ QYNFDRDNTE VAYLKTLTKE DIIKFYKEML AVDAPRRHKV SVHVLAREMD SCPVVGEFPC QNDINLSQAP ALPQPEVIQN MTEFKRGLPL FPLVKPHINF MAAKL (676-1019 aa encoded by BC096336)
靶标信息
This gene may belong to a protease family responsible for intercellular peptide signalling. Though its role in the cellular processing of insulin has not yet been defined, insulin-degrading enzyme is thought to be involved in the termination of the insulin response.
仅用于科研。不用于诊断过程。未经明确授权不得转售。
生物信息学
蛋白别名: Abeta-degrading protease; FLJ35968; Insulin degrading enzyme; Insulin protease; Insulin-degrading enzyme; Insulinase; Insulysin; unnamed protein product
基因别名: IDE; INSULYSIN
UniProt ID: (Human) P14735
Entrez Gene ID: (Human) 3416